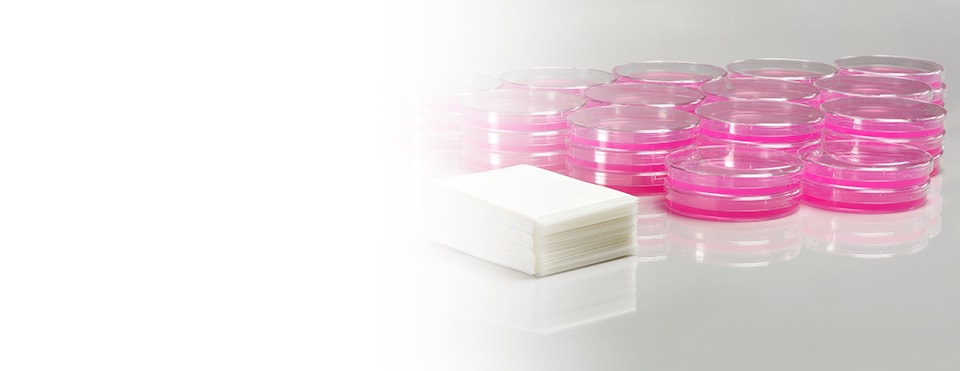
A photo of a stack of Petrifilm plates next to a much larger pile of petri dishes

-
Plating up food safety
March 01, 2016By Janna Fischer / 3M Storyteller


Plating up
food safetyThree decades ago, microbiologists around the globe let out a collective "WAHOO" as they were introduced to a new, more efficient and accurate way to detect bacteria in foods.
Until then, lab technicians spent hours preparing Petri dishes – a cumbersome and tedious process. Petrifilm Plates eliminated the need to prepare, purchase and store Petri dishes.Plating up
food safetyThree decades ago, microbiologists around the globe let out a collective "WAHOO!" as they were introduced to a new, more efficient and accurate way to detect bacteria in foods.
Until then, lab technicians spent hours preparing Petri dishes – a cumbersome and tedious process. Petrifilm Plates eliminated the need to prepare, purchase and store Petri dishes.


Passing the test
Food manufacturers test their products for possible bacteria, and they go through those tests like sweets.
Today, ready-to-use 3M Petrifilm Plates are an industry standard. There's a version for almost any kind of food-safety test - from E.coli and Listeria to Staph, Salmonella, yeast and mould.Passing the test
Food manufacturers test their products for possible bacteria, and they go through those tests like sweets.
Today, ready-to-use 3M Petrifilm Plates are an industry standard. There's a version for almost any kind of food-safety test - from E.coli and Listeria to Staph, Salmonella, yeast and mould.


Why does this matter to you?
Because the Food Standards Agency (FSA) estimates that one in 10 people in the UK will get sick this year from something they eat.
Ugh.Why does this matter to you?
Because the Food Standards Agency (FSA) estimates that one in 10 people in the UK will get sick this year from something they eat.
Ugh.

Somewhere behind many of the things you eat is someone testing to make sure your food is as safe as possible.
And the good news?
The paper-thin plates take up 85 per cent less space than traditional Petri dishes, which saves energy and significantly reduces waste.Somewhere behind many of the things you eat is someone testing to make sure your food is as safe as possible.
And the good news?
The paper-thin plates take up 85 per cent less space than traditional Petri dishes, which saves energy and significantly reduces waste.


Food that doesn't make you sick and is tested with less impact on the environment? Sounds delicious.
Food that doesn't make you sick and is tested with less impact on the environment? Sounds delicious.
3M food safety
